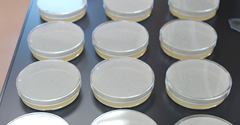

食品取扱者が病原性のある腸管出血性大腸菌等保有している場合、食品を汚染するリスクがあることから、健康、衛生管理としての検査が必要とされ、感染症法、学校給食法、大量調理施設衛生管理マニュアル等で検査が定められています。

保菌検査 |
・赤痢菌,腸チフス,パラチフス,サルモネラ
・腸炎ビブリオ |
・腸管出血性大腸菌O-157※
・腸管出血性大腸菌※
(O26、O103、O111、O121、O0145)
※平成28年度より実施
|
|
その他 |
・便潜血検査
・ノロウイルス検査 |
・寄生虫卵検査
|
|
詳しくは関連リンクからご確認ください。

●検査方法・・・・・リアルタイムPCR法・細菌培養法
●採取法・・・・・・採便容器
●保存条件・・・・・冷暗所保存
●採取注意事項・・・乾燥・漏れに注意する

ご依頼から報告書納品まで
|
検査依頼書の提出
お客様より検査依頼書をお送りください。 |


 |
|


|
検体の受領 |
|
|

|
検査 |
 |
|

|
報告書の提出 |
 |
|
|












|